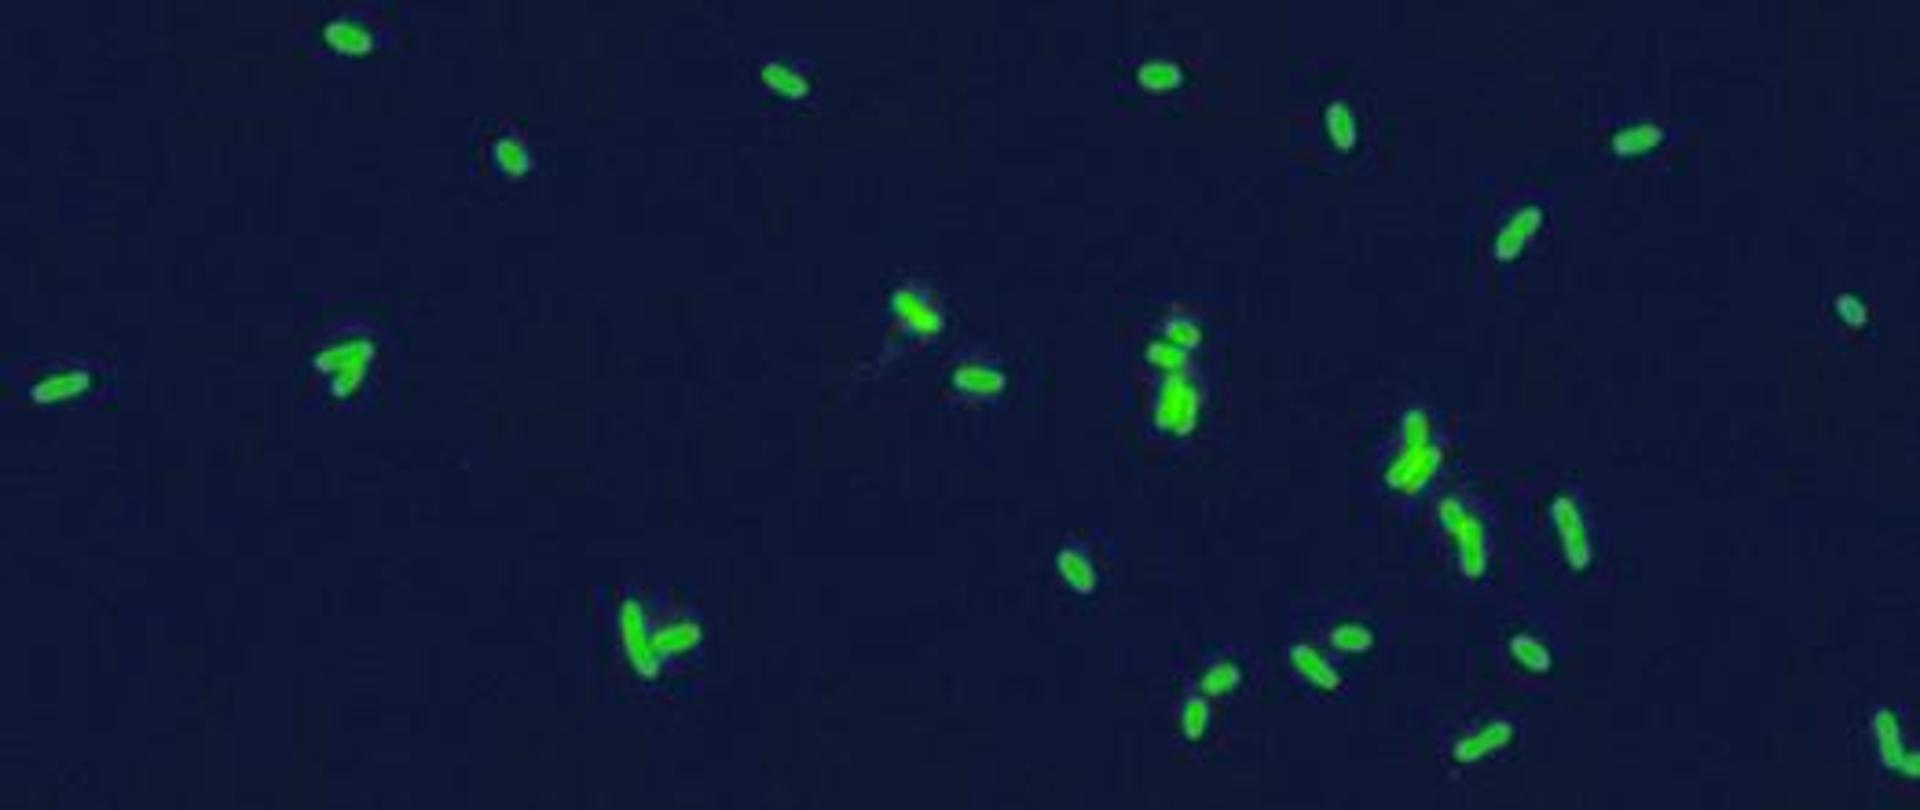

Actualités legionelloza-w-rzeszowie-nie-zyje-druga-osoba-mieszkancy-wykupuja-wode-ze-sklepow
Nie é¥yje kolejna osoba zakaé¥ona bakteriá Legionella
Thu, 24 Aug 2023 01:40:00 GMT
W szpitalu na Podkarpaciu zmaréa piá
ta osoba zakaé¥ona bakteriá
Legionella ... w Wirtualnej Polsce Krzysztof Boékowski ze szpitala miejskiego w Rzeszowie. Legionella zbiera émiertelne ...